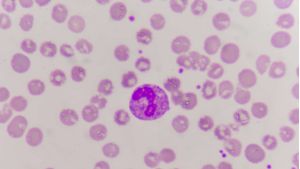

CCR26
The Best Critical Care Trials in the World
June 10th - 12th, 2026
Titanic Belfast, Belfast, Northern Ireland
Join us for the BIHCA trial results on Thursday, June 11th. Does bicarbonate help or harm during cardiac arrest? Or does it have little effect? We'll find out at CCR26.
CCR Meeting Talks
After 14 meetings, we have a huge collection of superb presentations. We'll showcase them here, one at a time.
CCR22 | FIRST-ABC Trial
Drs Padmanabhan Ramnarayan and Paul Mouncey (both London) present the results of the FIRST-ABC trial, comparing high-flow nasal cannulae therapy with CPAP in acute ill children with respiratory failure, at the Critical Care Reviews Meeting 2022. Dr Srinivas Murthy (Vancouver) delivers an editorial, which is followed by a panel discussion including Profs Kathryn Maitland (Kalifi), John Marshall (Toronto) and Marion Campbell (Aberdeen). The session is chaired by Prof Howard Bauchner.
added April 20th
FIRST-ABC (Step Down) Trial Presentation
Dr Padmanabhan Ramnarayan (London) and Mr Alvin Richards-Belle (London) present the results of the FIRST-ABC (Step Down) trial, comparing high flow nasal oxygen with continuous positive airway pressure in recently extubated children. This was presented during a Critical Care Reviews Livestream event.
Papers
CCR Trial Summaries & Critiques

RCT

RCT

RCT

Observational Study

Guideline

Guideline
added March 24th

Guideline

RCT

Commentary
added February 17th

Narrative Reviews
added February 17th
Foundational Trials Collection
After many months of preparation, we're delighted to release our Foundational Trials Collection.
250 critical care contemporary trials are summarised and critiqued in depth.
If you are new to the field, are undertaking exams, or just want to refresh your knowledge, this is an excellent place to start.
added February 17th

Sample Summaries
-
HEMOTION
-
ADRENAL
-
BLING III